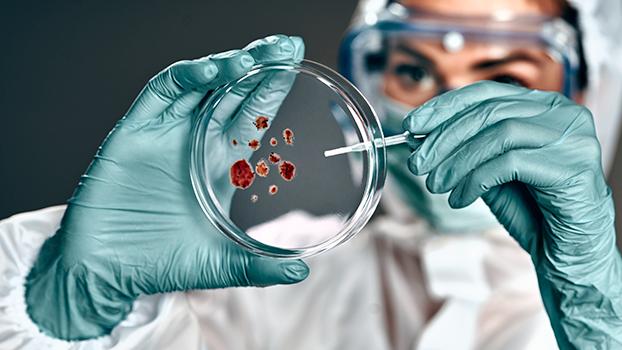
A biomedical specialist at work.

Biochemist
Biochemists investigate the chemical structure and processes of individual cells and their components, the organs and tissues in humans, animals, plants, and microorganisms. They study bodily organs and tissues through observation, dissection and microscopic examination. They also undertake detailed chemical analysis using sophisticated instruments and techniques. Biochemists may also study whole-of-organism processes such as digestion and growth, and may also prepare scientific reports based on their observations and experiments.
Working conditions
Biochemists usually work in scientific research institutes, universities and government organisations such as the Commonwealth Scientific and Industrial Research Organisation (CSIRO). Biochemists can also work in medical research centres and hospital laboratories and for food processing or drug manufacturing companies.
Biochemists in health and medical life sciences study the chemical processes of living organisms to understand diseases, develop treatments and improve diagnostics. They investigate the molecular basis of illnesses, design and test drug products and refine diagnostic tools by analysing blood and other fluids. Biochemists may also prepare scientific reports based on their observations and experiments. Ultimately, they serve as the molecular detectives of medicine, uncovering how life works at the chemical level to advance healthcare and improve patient outcomes.
Tools and technologies
Biochemists work with a wide array of standard and specialised laboratory equipment such as microscopes, filters, pumps, evaporators and centrifuges. They also rely heavily on advanced computer-assisted machines, which enable researchers to perform complex and highly specialised tests in a short period of time.
Biochemists in the health and medical life sciences industry work in laboratories in pharmaceutical, biotechnology and contract research organisations (CROs), universities and medical research institutes. They often work with hazardous chemicals and biological matter, which will require them to wear protective clothing.
When working with biological matter, biochemists need to use personal protective equipment. Most biochemists work regular business hours, however evening and weekend work may occasionally be required.
When working with biological matter, biochemists need to use personal protective equipment. Most biochemists work regular business hours, however evening and weekend work may occasionally be required.
Education and training
To become a biochemist; you typically need a university degree major in biochemistry, molecular biology, biomedical science or a related area. Curtin University, Murdoch University, University of Notre Dame and the University of Western Australia (UWA) offer courses in this field.
For details on course structure, entry requirements and application deadlines, please contact the educational institutions directly.
Free support and assistance
Your local jobs and Skills Centre can provide free information, support and assistance to help you decide on the best training options to meet your goals.
Disclaimer
The information presented on the occupation profiles within this website is offered as a guide only.

